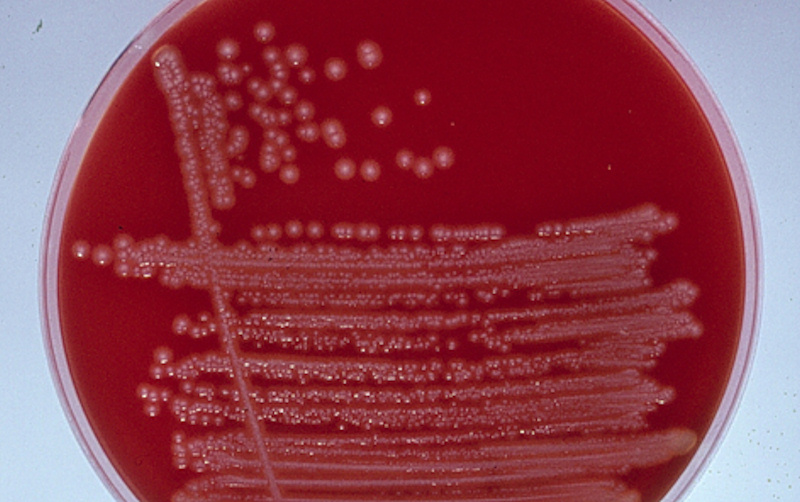

Darmkrankheiten und
bakterielle Enteritis bei Kaninchen
Esther van Praag, Ph.D.
|
MediRabbit.com wird nur dank den
Grosszügigkeit der Spender finanziert. Jede Spende, egal
wieviel, wird geschätzt und wird die ständige MediRabbit.com medizinischen Forschung über Versorgung und
Gesundheit der Kaninchen helfen. Danke |
ACHTUNG: Diese Seite könnte verstörende Bilder enthalten und
sollte von empfindlichen Menschen nicht betrachtet werden!!
|
Ein Kaninchen reagiert auf eine Reihe von Krankheiten
durch Darmstörungen, die sich als Durchfall auswirken. Die geschieht meist
bei 4 bis 10 Wochen alten Tieren, nur sehr selten bei Neugeborenen. Dies mag
daran liegen, dass diese haarlos und blind sind und deshalb das Nest nicht
verlassen, welches eine eigene in sich geschützte Welt darstellt. Der Durchfall bei Kaninchen wird durch vier
besondere Eigenschaften begünstigt: ·
Kaninchen sind leicht
reizbar, sie sind aber nicht in der Lage ihre Reaktionen (Adrenalinstöße) je nach
der Situation und ihrer Tragweite zu kontrollieren. ·
Kaninchen haben eine
besondere Darm-Physiologie, die als Caecotrophie bezeichnet wird. Dabei
werden bereits vorverdaute und fermentierte Teile (weiche
Ausscheidungskügelchen, Caecoptrophen) wieder durch Fressen in den
Verdauungsvorgang eingeschleust. Im Stress-Fall ergießt sich ein Hormon in
die Blutbahn, das das Nervensystem des Darms beeinflusst, den Verdauungsgang
stocken lässt und die Caecotrophie
anhält. ·
Nach einem Stress-Ereignis
(Alarm oder Angriff) wird das Caecum (Darminhalt) stärker alkalisch, was die
gesamte Darmumgebung beeinflusst. Dies wiederum hat Wirkung auf die Darmflora
(Bakterien) innerhalb derer sich pathogene Bakterien (z.B. Escherichia coli
oder Clostridium spp.) stark vermehren können. ·
Die äußere Erscheinung der
Krankheit, die durch die Stress-Situation ausgelöst wird, wird erst nach etwa
fünf bis sieben Tagen sichtbar, erst dann tritt der Durchfall auf.
Die Symptome von Verdauungsproblemen oder einer
Darmentzündungen sind bei Kaninchen einfach erkennbar und einheitlich. Erste Anzeichen,
die nach ein bis drei Tagen auftreten, werden normalerweise nicht
wahrgenommen. Das Tier frisst plötzlich weniger, danach tritt Verstopfung
auf. Weiche Ausscheidungen (Caecotrophen) werden nicht mehr erneut gefressen.
Nach dem fünften Tag tritt leichter Durchfall auf, begleitet von einer
Dehydration der Haut. Kleine Mengen flüssiger Ausscheidungen beschmutzen das
Hinterteil des Tieres. Der Tod kann in dieser Krankheitsphase bereits
auftreten, manchmal sogar vor Beginn des Durchfalls. Zwei oder drei Tage später
beginnt die akute Form der Krankheit. Weder Futter noch Flüssigkeit werden
aufgenommen, dieser Zustand wird bereits von starkem Durchfall begleitet. Die
Tiere knirschen mit den Zähnen als Reaktion auf innere Schmerzen und fallen
in ein Koma mit zuckenden Bewegungen. In diesem Zustand ist die Sterblichkeit
sehr hoch, es wurden aber auch Fälle beobachtet, in denen das Tier, selbst
nach einem vollen Tag Koma, überlebte und innerhalb weniger Tage voll genas. Eine post-mortem Untersuchung ergibt atypische
Wunden innerhalb des Darms. Während der akuten Krankheitsphase ist der
Darminhalt flüssig und überfüllt, die festen Bestandteile erscheinen
geschrotet. Der Darm ist gespannt, seine Wände sind mit roten Strichen
versehen, die Füllung besteht aus Gas und ein wenig Futterresten.
Ursachen
Für den
Durchfall gibt es eine Reihe von typischen und von außergewöhnlichen
Ursachen. Junge Tiere reagieren ungünstig auf eine
Ortsveränderung, besonders nach der Entwöhnung, aber auch auf
außergewöhnliche Geräuschsituationen, neue Umgebungen und neue Stallnachbarn
sowie auf neue Bezugspersonen. In gleicher Form können sich Ernährungsumstellungen
auswirken. Dabei ist das Futter selbst nicht unbedingt die Ursache, eher
seine Zusammensetzung, ein Fehlen von faserreichem Rohfutter, ein Überschuss
an Proteinen, zu fein gemahlenes Futter oder ungeeignete Wasserversorgung. Durchfall kann aber auch durch Anwesenheit
chemischer Stoffe entstehen wie Antibiotika (siehe „Gefahren für Kaninchen durch Antibiotika“) oder
Nitrate (im Trinkwasser). Viren und Bakterien können ebenfalls Enteritis
verursachen, dies durch anormale Entwicklung von Corynebakterien, Clostridia
sp., Pasteurella sp., und Eschericia
coli. Salmonellen treten bei Kaninchen
nur selten auf. Trematoden (Saugwürmer), Cestoden (Bandwürmer),
Nematoden (parasitischen Fadenwürmer) und
Protozoen (Coccidiosis) sind bekannte Darmparasiten,
die Durchfall bei Kaninchen hervorrufen. Coccidiose ist dabei die häufigste
und wichtigste Krankheitsursache. Bacterielle und
schleimige Enteritis
Schleimiger Durchfall tritt manchmal bei noch
nicht ausgewachsenen oder bei stillenden Tieren auf. Die weichen
Ausscheidungen sind dabei mit schleimiger, transparenter und gelatinöser
Masse gemischt. Diese besondere Art von Durchfall kann verschiedene Ursachen
haben, darunter auch Bakterien oder Ernährungsfehler (ungenügendes
Trinkwasser oder Mangel an Rohfaserfutter).
Bakterielle Enteritis
entwickelt sich sehr rasch innerhalb von 3 bis 4 Tagen und führt zum Tod des
Tieres sogar bevor der Durchfall auftritt. Die Bakterien, die diese Krankheit
verursachen sind bekannt, es sind die Clostridia perfringens und die Escherichia
coli. Bei gesunden Tieren findet man die Kolibazillen nur in geringer
Anzahl in den Fäkalien (10² bis 10³/g), bei Durchfall steigt die Anzahl
signifikant an. Escherichia coli wird gelegentlich
zusammen mit Kokkidien gefunden. Diese Bakterien produzieren Giftstoffe, es
ist aber nachgewiesen, dass diese nicht allein den Durchfall hervorrufen.
Erst zusätzlicher Stress wie unausgewogene Diät oder thermischer Schock lösen
erst die Krankheit aus. Clostridia
perfringens existiert in fünf
verschiedenen Formen, die nach den ausgeschiedenen Giftstoffen unterschieden
werden. Diese verursachen zumeist lokale Wunden in der Darmwand, ihre Wirkung
kann aber auch weiter streuen und Leber oder Niere angreifen.
Escherichia coli verfügt über fünf verschiedene Wirkungsweisen um
in den Darm einzudringen und die Krankheit hervorzurufen. Manchmal produzieren
sie auch Giftstoffe. Die Bakterien haften an den Darmzotten und vermehren und
verbreiten sich von dort. Die Anwesenheit der Giftstoffe regt die
Darmschleimhaut zur Sekretion von Wasser und Elektrolytflüssigkeit an. Die
Verbreitung der Bakterien zusammen mit den ausgeschiedenen Toxinen führt dann
zum Durchfall. Behandlung
Die Behandlung gegen
bakterielle Enteritis kommt oft zu spät, da sich die Krankheit sehr rasch entwickelt.
Antibiotika und Sulfonamide können aber zumindest die Ansteckung anderer
Tiere verhüten. Antibiotics and sulfonamide drugs will help prevent the growth of
pathogen bacteria. Anti-diarrhea product can help stop the diarrhea, e.g. Hylak, a concentrate of lactic ferments. The
administration of administration of cholestyramine will bind toxins released
by pathogen bacteria. Probiotic powders or paste, although controversial,
will help the growth of the endemic healthy bacterial flora. If the rabbit is
dehydrates, subcutaneous fluids should be given. In the case of yeast
overgrowth, this can be treated by reduced the carbohydrates sources in the
diet, or with nystatin. Danksagung
An dieser Stelle möchte ich mich beim Prof.
Richard Hoop (Institut für Veterinärbakteriologie, University of Zurich,
Switzerland), Kim Chilson (USA), Tal Saarony (USA) und weiteren Mitarbeiter
danken für die Bilder und die Kontrolle und Korrektur der Übersetzung. Thank
you to Adar, Flora, Stampi and Gozal for their help in illustrating this
article. Weitere InformationenBryskier A,
Doll J, Labro MT, Andrieu
J. Role of Clostridium and its toxin in pseudo-membranous colitis. Ann
Biol Clin (Paris). 1981;39(1):1-8. Jones
JR, Duff JP. Rabbit epizootic enterocolitis. Vet Rec. 2001 Oct 27;149(17):532. Hoop
RK, Ehrsam H, Keller B. 10
years of rabbit autopsy--a review of frequent disease and mortality causes. Schweiz Arch Tierheilkd. 1993; 135(6-7):212-6. Humphrey
CD, Condon CW, Cantey JR, Pittman FE. Partial
purification of a toxin found in hamsters with antibiotic-associated colitis.
Reversible binding of the toxin by cholestyramine. Gastroenterology. 1979 Mar;76(3):468-76. Licois D. Tyzzer's disease. Ann Rech Vet.
1986; 17(4):363-86. Sinkovics G.
Rabbit dysentery: 3. Diagnostic differentiation. Vet Rec. 1978 Oct 7;
103(15):331-2. Patton
NM, Holmes HT, Riggs RJ, Cheeke PR. Enterotoxemia in rabbits. Lab Anim
Sci. 1978; 28(5):536-40. Patton
NM, Holmes HT, Riggs RJ, Cheeke PR. Enterotoxemia in rabbits. Lab Anim
Sci. 1978; 28(5):536-40. Tribe
GW, Whitbread TJ, Watson GL. Fatal enteritis in rabbits associated with a spirochaete. Vet Rec. 1989; 124(22):595. |
|||||||||||||||
e-mail: info@medirabbit.com